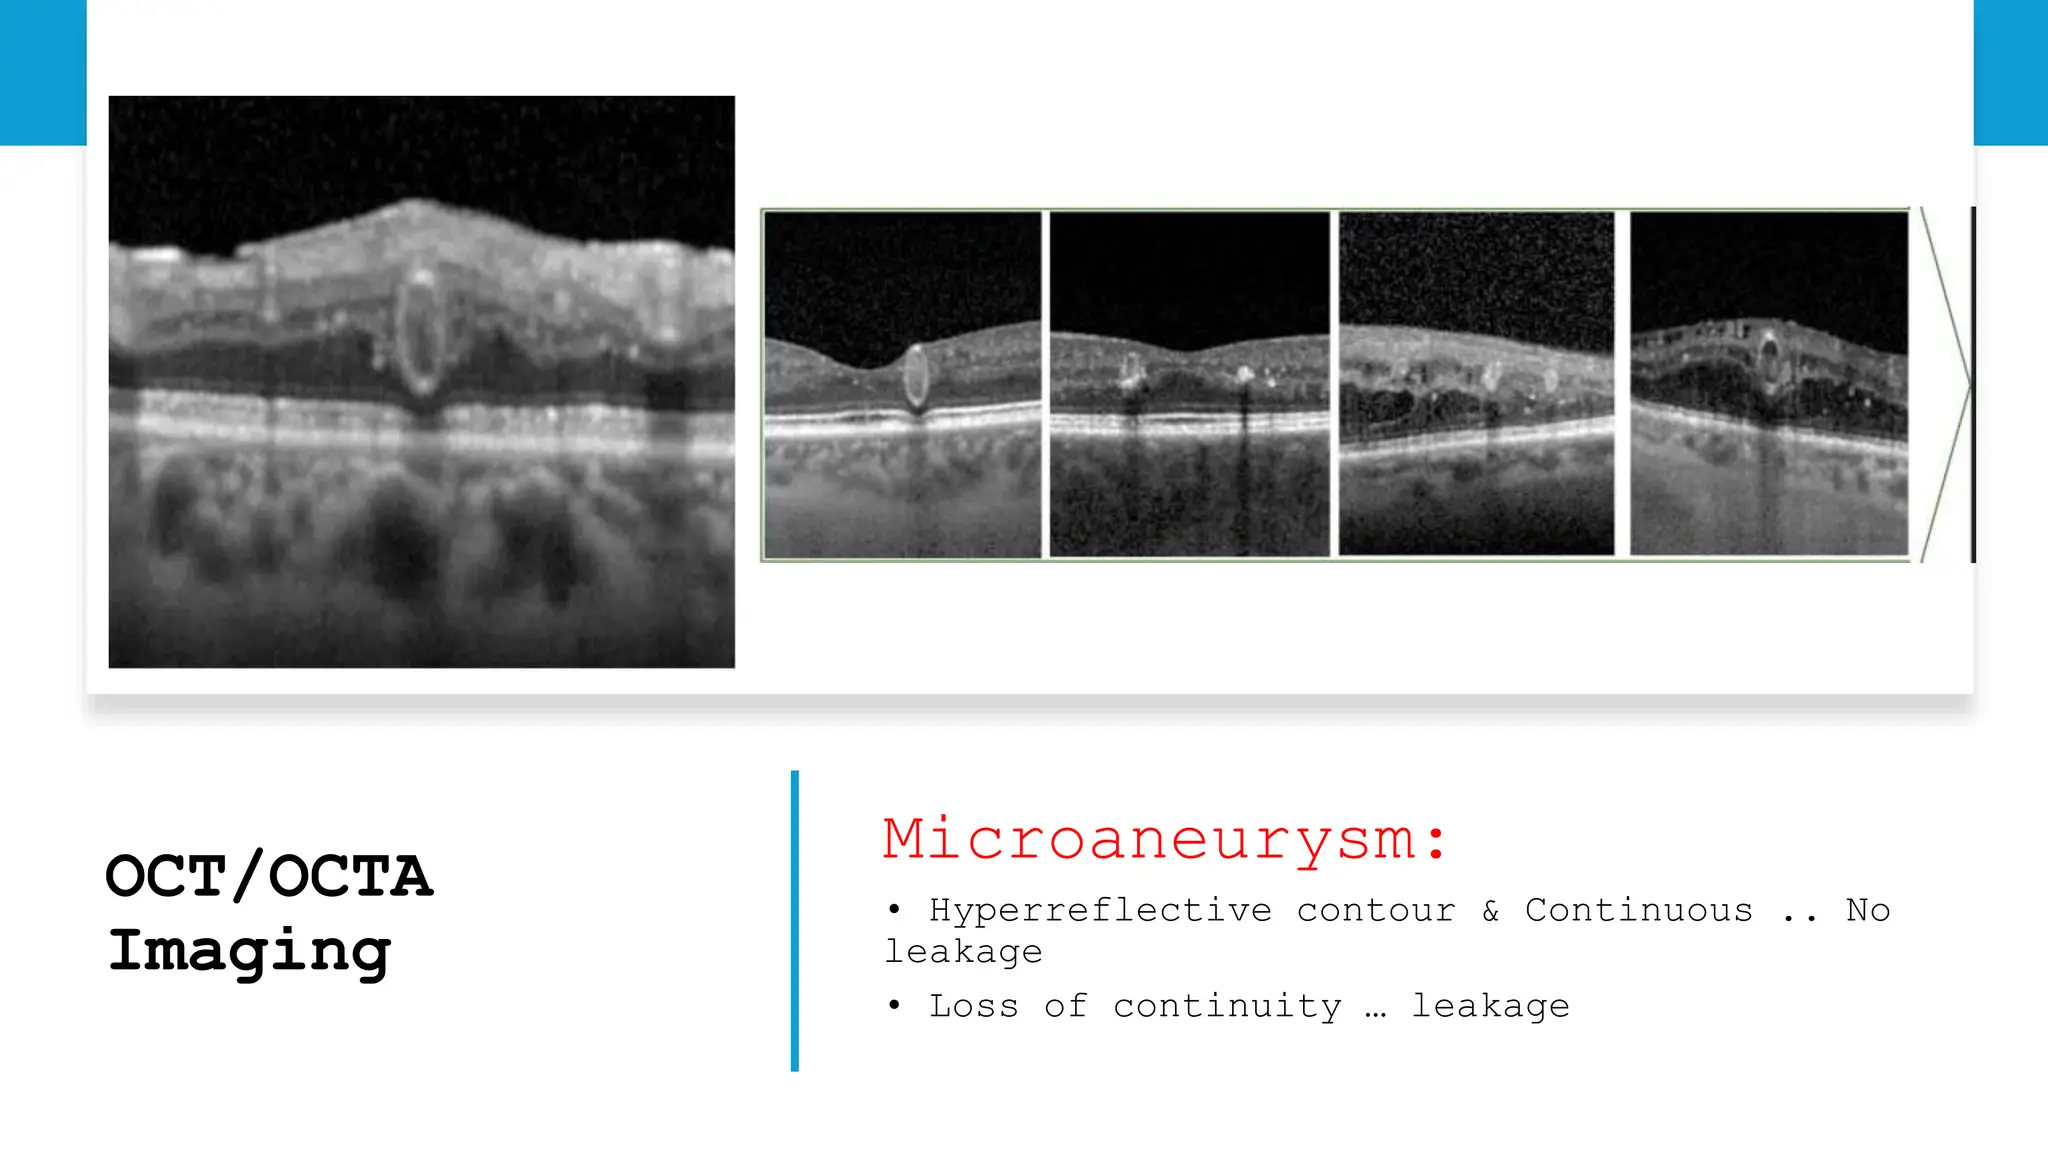
OCT/OCTA
Imaging
Microaneurysm:
• Hyperreflective contour & Continuous .. No
leakage
• Loss of continuity … leakage
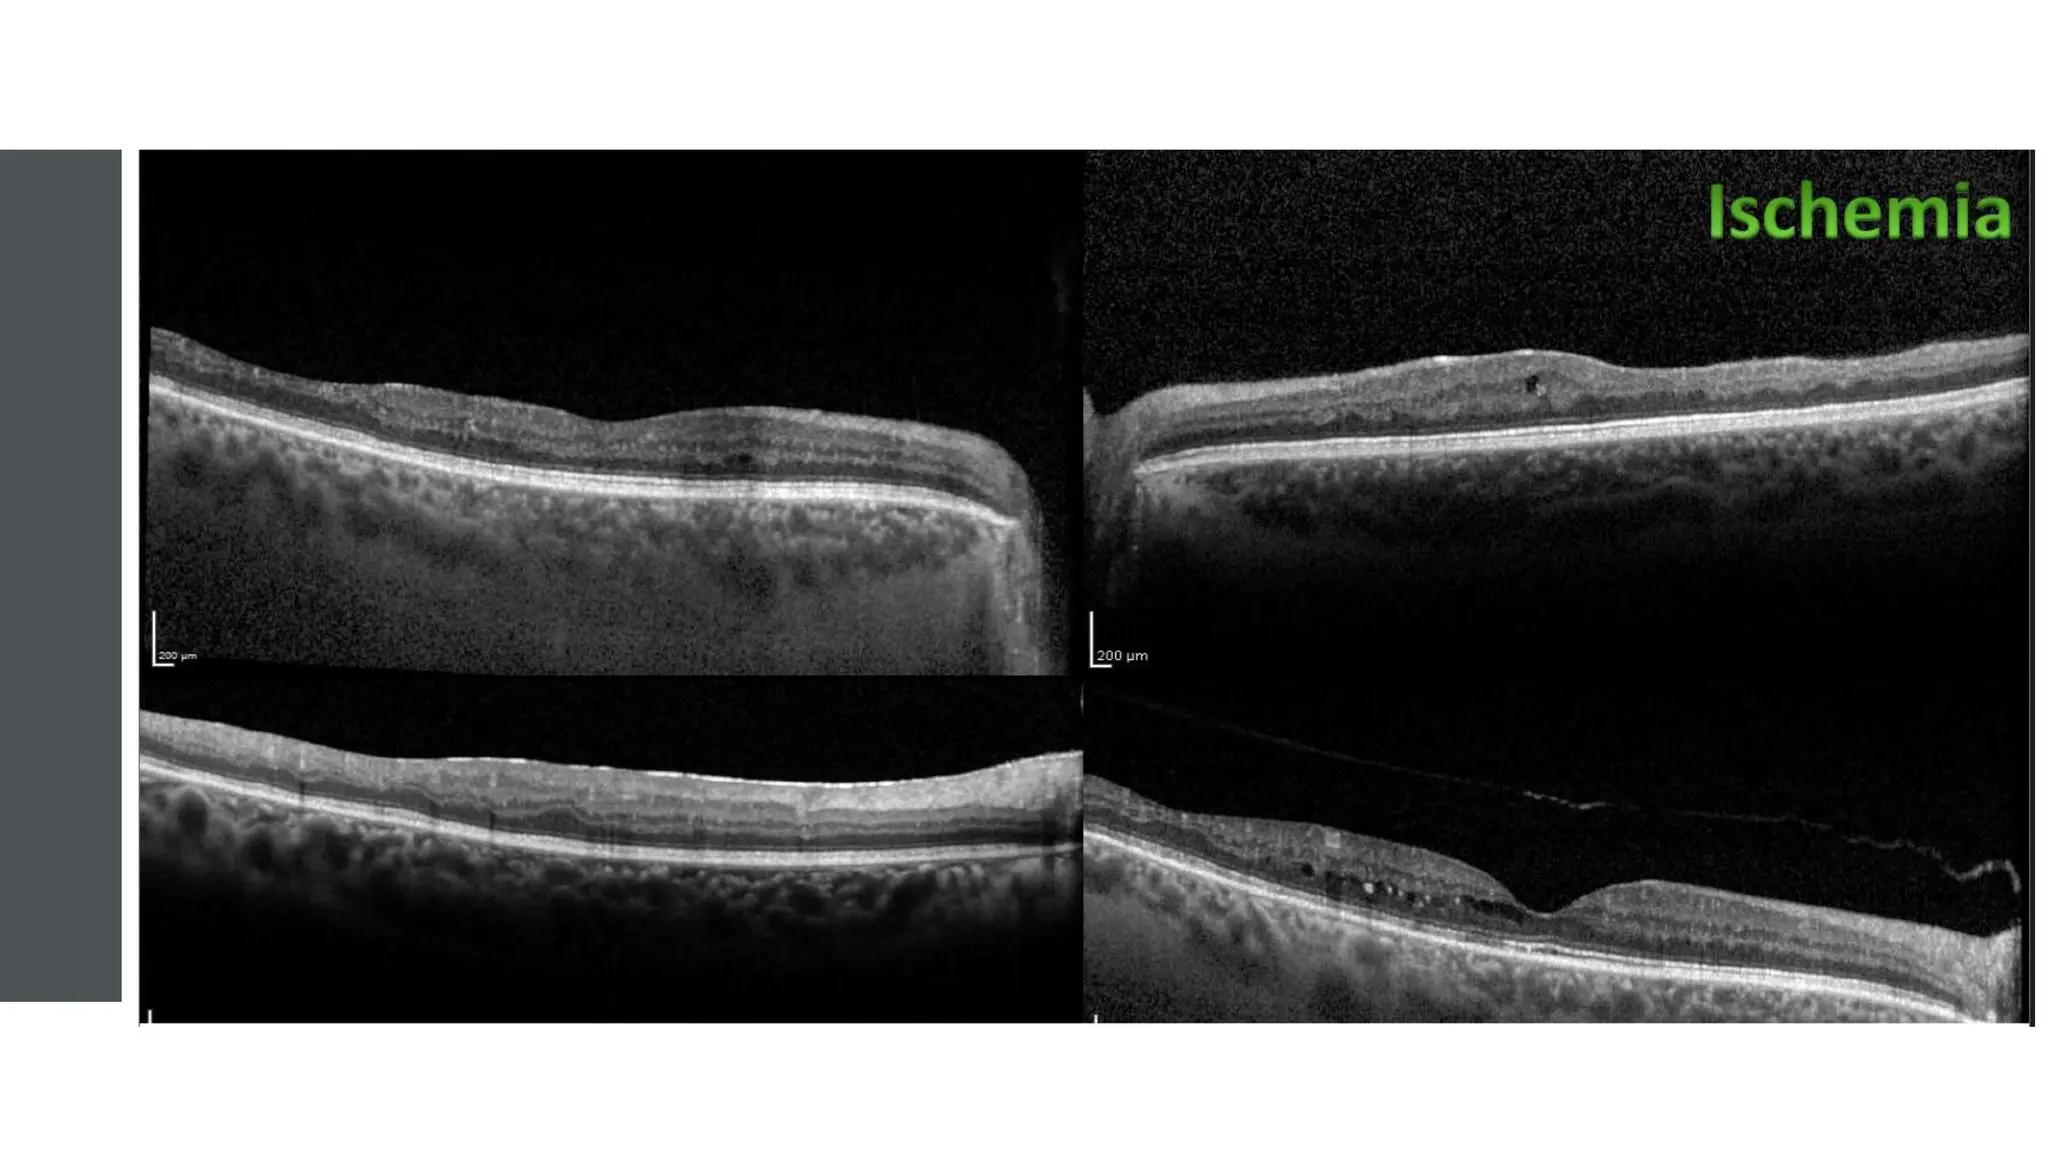

The document discusses diabetic retinopathy (DR) and the advancements in imaging technologies like ultra-wide field (UWF) imaging that enhance the classification and diagnosis of DR and diabetic maculopathy. It highlights the limitations of traditional methods, noting how UWF can capture a greater percentage of lesions and improve prognostic outcomes. Additionally, it details OCT-based classifications and the importance of various morphological features in assessing DR and planning surgical interventions.